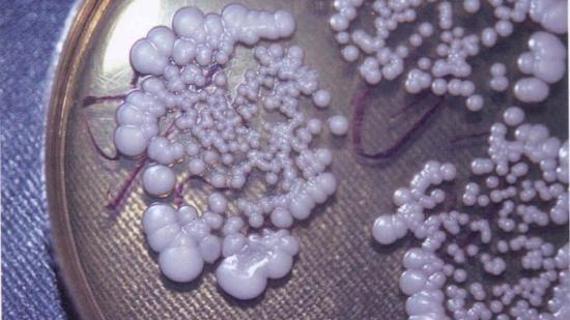

Можно ли вылечить аденому простаты народными средствами
Можно ли вылечить аденому простаты в домашних условиях?. Терапия аденомы предстательной железы проходит с применением разных лекарств...
6gtf 
Можно ли вылечить аденому простаты в домашних условиях?. Терапия аденомы предстательной железы проходит с применением разных лекарств...
6gtf 
Кора осины при аденоме простаты часто используется в лечении, благодаря своей безопасности и натуральному происхождению. Кора эффективно и быстро справляется с...
Muzhik.GURU 
Один из наиболее щадящих и безопасных способов лечения ДГПЖ – это лазерная вапоризация аденомы простаты. Метод подразумевает выпаривание ткани...
Простатиту - нет! 
Свечи от аденомы простаты эффективно избавляют от болезненности и дискомфорта, вызванных недугом. Для лечения можно использовать аптечные препараты или...
Muzhik.GURU 
Лечение аденомы предстательной железы и простатита солью при правильном применении показывает отличные результаты. Как готовить раствор и противопоказания...
Казанский гомеопат.центр 
Что такое хронический простатит? Можно ли окончательно вылечить хронический простатит? Какие существуют способы и методы лечения...
Ваш Проктолог 
Новые и самые современные методы лечения аденомы предстательной железы становятся открытием для многих пациентов. Большинство среди них относится к неоперативным...
Казанский гомеопат.центр 
Одной из самых неприятных и при этом распространенных проблем для мужчин после 45 является воспаление простаты. Патология представляет собой доброкачественное разрастание железистой ткани в зоне...
6i44 

Лечение заболеваний 


Казанский гомеопат.центр
Простатиту - нет! 
Простатиту - нет! 
Лечение заболеваний 


Лечение заболеваний 